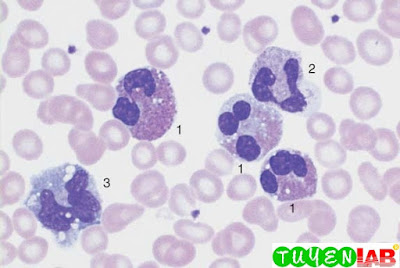

Lymphatic reactive states, Infectious Mononucleosis, CLL, Bone marrow cytology in CLL, Lymphoma of the B-cell and T-cell lineages, Mantle cell lymphoma, Hairy cell leukemia and splenic lymphoma, Reactive plasmacytosis and plasmacytoma, Atypical cells in multiple myeloma, The bone marrow in agranulocytosis, Reactive monocytosis and monocytic leukemia, Acute leukemia, Acute Lymphoblastic Leukemia (ALL), Myelodysplasia and CMML, Bone marrow analysis in myelodysplasia, Bone Marrow Analysis in CML, Acute blast crisis in CML., Osteomyelosclerosis (OMS), Elevated Eosinophil and Basophil Counts, atlas in medical, tuyenlab.net, HAEMATOLOGY ATLAS, SUBCLINICAL ATLAS
1. Reactive Lymphocytosis
10. Monocytosis
11. Acute leukemia, M0–M2
13. Acute leukemia M5 and M6Acute leukemia M5 and M6
14. AML with dysplasia and hypoplastic AML
15. Acute Lymphoblastic Leukemia (ALL)
16. Myelodysplasia (MDS)
18. Reactive Left Shift
19. CML
20. Bone Marrow Analysis in CML
21. Acute blast crisis in CML.
22. Osteomyelosclerosis (OMS).
23. Elevated Eosinophil and Basophil Counts
![]() |
| Fig. 1a. Lymphatic reactive states |
![]() |
| Fig. 1b. |
![]() |
| Fig. 1c. |
![]() |
| Fig. 1d. |
![]() |
| Fig. 1e. |
Lymphatic reactive states. a–e Wide variability of the lymphatic cells in a lymphotropic infection (in this case cytomegalovirus infection). Some of the cells may resemble myelocytes, but their chromatin is always denser than myelocyte chromatin.
2. Examples of Extreme Lymphocytic Stimulation: Infectious Mononucleosis
![]() |
| Fig. 2a. “Blastic,” lymphatic reactive form (Pfeiffer cell), in addition to less reactive virocytes in Epstein–Barr virus (EBV) infection. This phase with blastic cells lasts only a few days. |
![]() |
| Fig. 2b. Virocyte (1) with ho- mogeneous deep blue stained cytoplasm in EBV infection, in addition to normal lymphocyte (2) and monocyte (3). |
![]() |
| Fig. 2c. Virus infection can also lead to elevated counts of large granulated lymphocytes (LGL) (1). Monocyte (2). |
![]() |
| Fig. 2d. Severe lymphatic stress reaction with granulated lymphocytes. A lymphoma must be considered if this finding persists. |
3. Monotonous proliferation of small lymphocytes suggests chronic lymphocytic leukemia (CLL)
![]() |
| Fig. 3a. Extensive proliferation of lymphocytes with densely structured nuclei and little variation in CLL. Nuclear shadows are frequently seen, a sign of the fragility of the cells |
![]() |
| Fig. 3b. Lymphocytes in CLL with typical coarse chromatin structure and small cytoplasmic layer |
![]() |
| Fig. 3c. Slightly eccentric enlargement of the cytoplasm in the lymphoplasmacytoid variant of CLL. |
![]() |
| Fig. 3d. Proliferation of atypical large lymphocytes (1) with irregularly struc- tured nucleus, weldefined nucleolus, and wide cytoplasm (atypical CLL or transitional form CLL/PLL) |
![]() |
| Fig. 3e. Bone marrow cytology in CLL: There is always strong proliferation of the typical small lymphocytes, which are usually spread out diffusely |
4. Atypical lymphocytes are not part of B-CLL
![]() |
| Fig. 4a. Prevalence of large lymphocytes with clearly defined nucleoli and wide cytoplasm: prolymphocytic leukemia of the B-cell series (B-PLL). |
![]() |
| Fig. 4b. The presence of large blastic cells (arrow) in CLL suggest a rare transformation (Richter syndrome). |
![]() |
| Fig. 4c. The rare Sézary syndrome (T-cell lymphoma of the skin) is characterized by irregular, indented lymphocytes. |
![]() |
| Fig. 4d. Prolymphocytic leukemia of the T-cell series (T-PLL) with indented nuclei and nucleoli (rare) |
![]() |
| Fig. 5a. Fine, dense chromatin and small indentations of the nuclei suggest migration of leukemic mantle cell lymphoma cells into the blood stream. |
![]() |
| Fig. 5b. Denser chromatin and sharp indentations suggest migration of follicular lymphoma cells into the blood stream |
6. Lymphoma, Usually with Splenomegaly (e.g., Hairy Cell Leukemia and Splenic Lymphoma with Villous Lymphocytes)
![]() |
| Fig. 6a. Ovaloid nuclei and finely “fraying” cytoplasm are characteristics of cells in hairy cell leukemia (HCL). |
![]() |
| Fig. 6b. Ovaloid nuclei and finely “fraying” cytoplasm are characteristics of cells in hairy cell leukemia (HCL). |
![]() |
| Fig. 6c. Occasionally, the hairy cell processes appear merely fuzzy. |
![]() |
| Fig. 6d. |
![]() |
| Fig. 6e. |
d and e When the cytoplasmic processes look thicker and much less like hair, diagnosis of the rare splenic lymphoma with villous lymphocytes (SLVL) must be considered. Here, too, the next diagnostic step is analysis of cell surface markers.
7. Monoclonal Gammopathy (Hypergammaglobulinemia), Multiple Myeloma*, Plasma Cell Myeloma, Plasmacytoma
![]() |
| Fig. 7b. Extensive (about 50 %) infiltration of the bone marrow of mostly well-differentiated plasma cells: multiple myeloma. |
8. Variability of Plasmacytoma Morphology
![]() |
| Fig. 8a. Extensive infiltration of the bone marrow by loosely structured, slightly dedifferentiated plasma cells with wide cytoplasm in multiple myeloma. |
![]() |
| Fig. 8b. In multiple myeloma, vacuolated cytoplasmic protein precipitates (Russell bodies) may be seen in plasma cells but are without diagnostic significance. |
![]() |
| Fig. 8c. Binuclear plasma cells are frequently observed in multiple myeloma (1). Mitotic red cell precursor (2). |
![]() |
| Fig. 8d. Differential diagnosis: red cell precursor cells can sometimes look like plasma cells. Proerythroblast (1) and basophilic erythroblast (2). |
9. Relative Lymphocytosis Associated with
Granulocytopenia (Neutropenia) and Agranulocytosis
![]() |
| Fig. 9b. Bone marrow in agranulocytosis during the promyelocytic phase, showing almost exclusively promyelocytes (e.g., 1); increased eosinophilic granulocytes (2) are also present. |
![]() |
| Fig. 10a. Reactive and neoplastic monocytes are morphologically indistinguishable; here two relatively condensed monocytes in reactive monocytosis are shown. |
![]() |
| Fig. 10b. Whenever monocytes are found exclusively, a malignant etiology is likely: in this case AML M5 b according to the FAB classification. Auer bodies (arrow). |
![]() |
| Fig. 10c. Monocytes of different degrees of maturity, segmented neutrophilic granulocytes (1), and a small myeloblast (2) in chronic myelomonocytic leukemia |
![]() |
| Fig. 11c. |
![]() |
| Fig. 11d. |
c and d Variants of M2 leukemia. Some of the cells already contain granules (1) and crystal-like Auer bodies (2).
12. Acute leukemia M3 and M4.
![]() |
| Fig. 12a. Blood analysis in promyelocytic leukemia (M3): copious cytoplasmic granules. |
![]() |
| Fig. 12b. In type M3, multiple Auer bodies are often stacked like firewood (so-called faggot cells). |
![]() |
| Fig. 12c. Blood analysis in variant M3 v with dumbbell-shaped nuclei. Auer bodies |
![]() |
| Fig. 12d. Bone marrow cytology in acute myelomonocytic leukemia M4: in addition to myeloblasts (1) and promyelocytes (2) there are also monocytoid cells (3). |
![]() |
| Fig. 12e. In variant M4Eo abnormal precursors of eosinophils with dark granules are present. |
![]() |
| Fig. 12f. Esterase as a marker enzyme for the monocyte series in M4 leukemia. |
13. Acute leukemia M5 and M6Acute leukemia M5 and M6
![]() |
| Fig. 13a. In monoblastic leukemia M5 a, blasts with a fine nuclear structure and wide cytoplasm dominate the CBC. |
![]() |
| Fig. 13b. Seemingly mature monocytes in monocytic leukemia M5 b. |
![]() |
| Fig. 13c. Homogeneous infiltration of the bone marrow by monoblasts (M5 a). Only residual granulopoiesis (arrow). |
![]() |
| Fig. 13d. Same as c but after esterase staining. The stage M5 a blasts show a clear positive reaction (red stain). There is a nonspecific-esterase (NSE)-negative promyelocyte. |
![]() |
| Fig. 13e. Same as c Only the myelocyte in the center stains peroxidase-positive (brown tint); the monoblasts are peroxidase-negative. |
14. AML with dysplasia and hypoplastic AML
![]() |
| Fig. 14a. AML with dysplasia: megaloblastoid (dysplastic) erythropoiesis (1) and dysplastic granulopoiesis with Pelger- Huët forms (2) and absence of granulation in a myelocyte (3). Myeloblast (4). |
![]() |
| Fig. 14b. Multiple separated nuclei in a megakaryocyte (1) in AML with dysplasia. Dyserythropoiesis with karyorrhexis (2). |
![]() |
| Fig. 14c. Cell numbers be- low normal for age in the bone marrow |
![]() |
| Fig. 14d. Magnification of the area indicated in c, showing predominance of undifferentiated blasts (e.g., 1). |
15. Acute Lymphoblastic Leukemia (ALL)
![]() |
| Fig. 15a. Screening view: blasts (1) and lymphocytes (2) in ALL. Further classification of the blasts requires immunological methods (common ALL). |
![]() |
| Fig. 15b. The blasts show a dense, irregular nuclear structure and narrow cytoplasm. Lymphocyte (2). |
![]() |
| Fig. 15c. ALL blasts with indentations must be distinguished from small-cell non-Hodgkin lymphoma by cell surface marker analysis. |
![]() |
| Fig. 15d. Bone marrow: large, vacuolated blasts, typical of B-cell ALL. The image shows residual dysplastic erythropoietic cells (arrow). |
![]() |
| Fig. 16a. |
![]() |
| Fig. 16b. |
![]() |
| Fig. 16c. |
a–c Different degrees of abnormal maturation (pseudo-Pelger type); the nuclear density can reach that of erythroblasts
![]() |
| Fig. 16d. The cytoplasmic hypogranulation is also observed in normal segmented granulocytes. These abnormalities are seen in myelodysplasia or after chemotherapy, among other conditions. |
![]() |
| Fig. 16e. Blood analysis in CMML: monocytes (1), promyelocyte (2), and pseudo-Pelger cell (3). Thrombocytopenia |
17. Bone marrow analysis in myelodysplasia
![]() |
| Fig. 17a. Dysmegakaryopoiesis in myelodysplastic syndrome (MDS). Relatively small disk-forming megakaryocytes (1) and multiple singular nuclei (2) are often seen. |
![]() |
| Fig. 17b. Mononuclear megakaryocytes (frequent in 5 q-syndrome) |
![]() |
| Fig. 17c. Dyserythropoiesis. Particularly striking is the coarse nuclear structure with very light gaps in the chromatin (arrow 1). Some are megaloblast-like but coarser (arrow 2). |
![]() |
| Fig. 17d. Iron staining of the bone marrow (Prussian blue) in myelodysplasia of the RARS type: dense iron granules forming a partial ring around the nuclei (ring sideroblasts). |
18. Reactive Left Shift
![]() |
| Fig. 18a. |
![]() |
| Fig. 18b. |
a and b Typical blood smear after bacterial
infection: toxic granulation
in a segmented granulocyte (1), monocyte with gray–blue
cytoplasm (2),
metamyelocyte (3), and myelocyte (4).
![]() |
| Fig. 18c. Blood analysis in sepsis: promyelocyte (1) and orthochromatic erythroblast (2). Thrombocytopenia. |
![]() |
| Fig. 18d. |
![]() |
| Fig. 18e. |
d and e Reactive left shift as far as promyelocytes (1).
Particularly striking are the reddish granules in a band neutrophilic granulocyte (2).
![]() |
| Fig. 19b. |
![]() |
| Fig. 19c. |
b and c Also chronic phase: myeloblast (1), promyelocyte (2), myelocyte with defective granulation (3), immature eosinophil (4), and basophil (5) (the granules are larger and darker, the nuclear chromatin denser than in a promyelocyte).
![]() |
| Fig. 20b. Often micromegakaryocytes are found in the bone marrow cytology. |
![]() |
| Fig. 20c. Pseudo-Gaucher cells in the bone marrow in CML. |
21. Acute blast crisis in CML.
![]() |
| Fig. 21b. Myeloblasts in an acute CML blast crisis. Typical sand-like chromatin structure with nucleoli. A lymphocyte. |
![]() |
| Fig. 21c. Bone marrow cytology in acute CML blast crisis: blasts of variable sizes around a hyperlobulated megakaryocyte (in this case during a lymphatic blast crisis). |
22. Osteomyelosclerosis (OMS).
![]() |
| Fig. 22a. |
![]() |
| Fig. 22b. |
a and b Screening of blood cells in OMS: red cell precursors (orthochromatic erythroblast = 1 and basophilic erythroblast = 2), basophilic granulocyte (3), and teardrop cells (4).
![]() |
| Fig. 22c. Sometimes small, dense megakaryocyte nuclei are also found in the blood stream in myeloproliferative diseases. |
![]() |
| Fig. 22d. Blast crisis in OMS: myeloblasts and segmented basophilic granulocytes (1). |
23. Elevated Eosinophil and Basophil Counts
![]() |
| Fig. 23a. Screening view of blood cells in reactive eosinophilia: eosinophilic granulocytes (1), segmented neutrophilic granulocyte (2), and monocyte (3) (reaction to bronchial carcinoma). |
![]() |
| Fig. 23b. |
![]() |
| Fig. 23c. |
b and c The image shows an eosinophilic granulocyte (1) and a
basophilic granulocyte (2) (clinical osteomyelosclerosis).
This is only a part of the book : Color Atlas of Hematology: Practical Microscopic and Clinical Diagnosis (Clinical Sciences) 2nd of authors: Harald Theml, M.D; Heinz Diem, M.D and Torsten Haferlach, M.D. If you want to view the full content of the book and support author. Please buy it here: https://goo.gl/sxasqM

COMMENTS